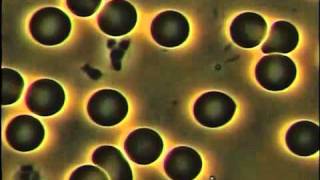

Basics
Let’s make sure you know the basics about what essential oils are, why you want to purchase doTERRA essential oils, how to use them, and how to get the best price possible.
1. Glimpse Inside doTERRA
This introductory video is about 10 minutes but well worth a glimpse inside doTERRA.
2. What are essential oils?
Essential oils are aromatic compounds from the leaves, flowers, bark, roots, seeds, or rinds of different plants. Since they are aromatic, they will evaporate if the bottle is left open and will immediately absorb into the skin. Here is a quick video to help illustrate:
3. How do you use essential oils?
There are 3 ways to use essential oils: topically (touch), aromatically (smell), and internally (taste).
We use oils topically for a specific spot we might need it like a sick stomach, a sore knee, head tension, or a sore back. We can also place the oils of the bottoms of the feet for fast absorption or if you just don’t like the smell of one you really need.
Here is a quick video to illustrate how quickly oils work after placing them on the bottoms of the feet:
Then we can use oils aromatically by inhaling right out of the bottle, from a diffuser, or a drop within our hands then cupped over our nose and mouth to breathe in deeply for several minutes.
Lastly, we use them internally. This is recommended for doTERRA oils only. We would do this for organ cleansing, immune boosting, throat trouble, cellular support, or over all body cleansing.
Watch these videos to see me explaining each of the three ways to use essential oils:
4. Why doTERRA?
Why would you choose doTERRA over some cheaper brands?
Watch this video for a glimpse:
doTERRA coined the term CPTG which stands for Certified Pure Therapeutic Grade for their own standard to regulate their own oils since no oils are regulated by the FDA. It means that each and every batch of oil that comes in, will be the exact same as the last. If a batch of oil comes in and does not meet their standard, they will not sell the batch to us. doTERRA wants to be as tranparent as possible so they have an awesome site called sourcetoyou.com. You are invited to type in the batch number off the bottom of each bottle as actually view the results of the batch to ensure purity and quality.
How to Find Good Oils
Various brands of, so called, ‘essential oils’ can be seen at Walmart, Best Buy, Target and random health food stores. Knowing what to look for to spot a quality essential oil is key. Here are some clues and red flags for you:
-
Are the oils greasy or oily to the touch? Well, they shouldn’t be. Pure essential oils immediately absorb into the skin leaving no trace other than a pleasant aromatic effect. If they do immediately absorb, then you might have found a somewhat good oil. Now it comes down to the desired effect of the oil, potency, and purity.
-
If you were to leave a bottle of doTERRA oils open, it would completely evaporate since the compounds are aromatic.
-
Does it smell like it says on the bottle? I challenge you to go and touch and smell some of the oils at your local health food store. You will see what I mean.
-
Do oils from food that we normally consume like cinnamon, lemon, lime, orange, and peppermint say on the bottle “not for internal use”? If we put sliced lemons in our lemonade and mint in our teas, which have the essential oils attached, then why can I not consume them? Truth is, if you normally eat it, then you can use the essential oil internally also.
Can I get doTERRA on Amazon or eBay?
If you happen to see doTERRA essential oils on Amazon or eBay, they may seem cheaper. When it comes to retail purchases, they are. Here are some things you need to be aware of about Amazon and eBay purchasing.
-
doTERRA is having a lot of problems with people calling in and complaining that the oils are not the “same” as when they purchased them from doTERRA itself. People are adulterating them and recapping them.
-
There is a price curve depending on who is selling it…which they should not be in the first place.
-
You actually get better pricing when you become a wholesale customer. You get 25% off retail and you have an option to earn FREE product with points you earn through your purchases AND shipping is always credited back to your account in product credit. You also get team support and education. Essential oils definitely have a learning curve and education is VERY important!
5. What is the best way to purchase essential oils from doTERRA?
Let me share! Becoming a wholesale customer is the best way of course! It saves you 25%-55% off the retail price! Here is a quick video to explain:
Learn more about how to become a doTERRA wholesale customer and save 25-55% when you buy oils.







